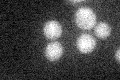
YMR041C
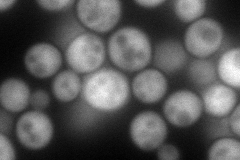
YMR041C
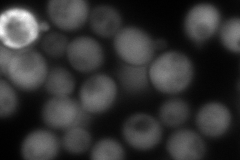
YMR041C
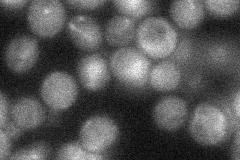
YMR041C
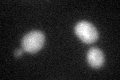
YMR041C
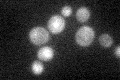
YMR041C

View description
NAD-dependent arabinose dehydrogenase, involved in biosynthesis of dehydro-D-arabinono-1,4-lactone; similar to plant L-galactose dehydrogenase
Localization:
Intensity:
Fold change:
Significance:
-
C’ GFP library in SD
below threshold16.76 -
N' NOP1pr-GFP in SD
cytosol131.197 -
N' TEF2pr-mCherry in SD
cytosol230.094 -
N' NATIVEpr-GFP in SD
cytosol27.3952 -
N' TEF2pr-VC and Cyto-VN in SD

cytosol71.0776 -
C’ GFP library in SD+DTT
cytosol20.261.2No -
C’ GFP library in SD+H2O2

cytosol20.421.21No -
C’ GFP library in Starvation Media
cytosol33.421.99No -
C’ GFP library on the background of Pup2-DaMP

below threshold -
C’ GFP library on the background of CCT mutant

below threshold17.8611.06525No
